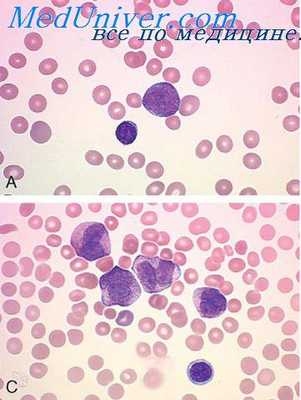
механическая асфиксия

Механическая асфиксия. Сдавление органов шеи петлей
Добавил пользователь Cypher Обновлено: 28.11.2025
Механическая асфиксия. Сдавление органов шеи петлей
Понятие о механической асфиксии используют в судебной медицине условно для обозначения различных видов механического нарушения внешнего дыхания. Оно может быть вызвано сдавлением шеи, груди и живота, закрытием дыхательных путей каким-либо предметом, попаданием в дыхательные пути инородного тела, сыпучих веществ, жидкостей.
Судебно-медицинская диагностика смерти в этих случаях основывается на обнаружении и исследовании характерных видовых признаков — следов механического воздействия и нехарактерных, так называемых общеасфиктических, признаков быстро наступившей (острой) смерти. Наряду с макроскопическим исследованием важное значение имеет микроскопическое исследование этих признаков.
Различают три основных типа сдавленпя органов шеи: повешение, удавление петлей, удавление руками.
Сдавление органов шеи петлей. Важным диагностическим признаком смерти от сдавлепия органов шеи петлей (при повешении или удавлении петлей) является странгуляционная борозда. Этим термином обозначают след на шее, образованный петлей. Борозда может окружать всю шею или занимать только часть ее окружности. При повешении расположение борозды на шее определяется положением тела в петле и узла на шее. Она обычно имеет косовосходящее направление назад, вперед или к боковой поверхности шеи.
Ширина борозды зависит от ширины и толщины петли, а глубина — от толщины и степени жесткости петли и положения тела в петле.
В бороздах различают дно, краевые и промежуточные валики.
В зависимости от материала петли на коже шеи могут образовываться так называемые перга ментированпые н мягкие странгуляционные борозды.
Для микроскопического исследования вырезают кусочки кожи с таким расчетом, чтобы в них были представлены дно и краевые валики борозды и неповрежденная кожа. При наличии мышечной борозды следует также взять кусочек мышцы, где борозда наиболее отчетлива. В кусочках кожи и мышц нижний край борозды маркируют этикеткой. Берут также кусочки внутренних органов.
Изменения в коже и мышцах шеи находятся в определенном соответствии с макроскопическим видом борозды (пергаментированная и мягкая).
Пергаментированная борозда. Эпидермис резко чплощен, поверхностные его слои отсутствуют. В препаратах, окрашенных гематоксилин-эозином, сохранившиеся участки имеют бурый вид; гематоксилином (по Шппльмейеру) красятся в черный, а пикрокармин-нндигокармпном (по Митяевой Н. Л.) — в зеленый нвет.
Ядра клеток имеют резко вытянутую форму, иногда напоминают штрихи, расположенные параллельно поверхности кожи, окрашенные гематоксилином интенсивно. На отдельных участках клеточная структура эпидермиса неразличима. Степень изменений эпидермиса уменьшается по направлению к нижнему краевому валику.
В собственно коже сосочковый слой почти не определяется, сетчатый представляется компактным, однако волокнистое строение сохранено. Коллагеновые волокна сближены, в состоянии различной степени гомогенизации и выраженной базофилии, которая выявляется при окраске гематоксилин-эозином и железным гематоксилином по Шпильмейеру. В последнем случае на месте борозды волокна приобретают черный цвет, а за ее пределами остаются светлыми.
Аналогичное избирательное восприятие краски соединительной тканью в пределах борозды можно увидеть на препаратах, окрашенных сафранином, основным фуксином, генциановым и метиленовым фиолетовым (волокна окрашиваются в соответствующий краске цвет). С помощью других красителей можно обнаружить явления метахромазии. Так, при окраске пикрокармин-индигокармином коллагеновые волокна приобретают лазоревый цвет, тогда как за пределами борозды — фиолетово-красный, а при окраске крезил фиолетовым — соответственно синий и фиолетовый цвет.
Ядра соединительнотканных клеток на месте борозды часто не выявляются. Эластические волокна фрагментированы. Сосуды сдавлены, крови не содержат, имеют вид продольно расположенных клеточных тяжей. В то же время по краям борозды определяется выраженная гиперемия, могут обнаруживаться кровоизлияния; последние иногда находят и в области дна борозды.
В некоторых случаях при двойных, тройных и т. д. петлях наблюдают промежуточные валики. Под микроскопом они напоминают пирамиду. На вершине ее эпидермис изменен мало, а по бокам значительно, как и на дне борозды. В соединительной ткани изменения аналогичны приведенным выше. Сосуды большей частью пустые.
Информация на сайте подлежит консультации лечащим врачом и не заменяет очной консультации с ним.
См. подробнее в пользовательском соглашении.
Асфиксия
Асфиксия – это состояние удушья, сопровождающееся критическим падением уровня кислорода (гипоксией) и избытком углекислого газа (гиперкапнией) в крови и тканях. При асфиксии остро или подостро нарастают явления дыхательной недостаточности: синюшность кожи, тахипноэ, участие в дыхании вспомогательной мускулатуры; в терминальной стадии развивается кома, судороги, остановка дыхания и сердечной деятельности. Состояние асфиксии диагностируется на основании оценки жалоб и физикальных данных, пульсоксиметрии. В этом случае требуется оказание неотложной помощи, которая включает в себя восстановление проходимости дыхательных путей, ингаляции кислорода, трахеотомию, ИВЛ, медикаментозную терапию.
МКБ-10
Общие сведения
Асфиксия (asphyxia; греч. - а - отрицание + sphyxis - пульс; буквально - "отсутствие пульса") – жизнеугрожающее состояние, связанное с нарушением газообмена, развитием гипоксического и гиперкапнического синдромов и приводящее к расстройству дыхания и кровообращения. В основе асфиксии может лежать дисфункция дыхательного центра, механическое препятствие для поступления воздуха в легкие, поражение дыхательной мускулатуры. Все виды и формы асфиксии, независимо от причин, требуют проведения неотложных (а иногда и реанимационных) мероприятий, поскольку уже через несколько минут после развития острого кислородного голодания, может наступить смерть. В медицине проблема асфиксии актуальна для неонатологии, пульмонологии, травматологии, токсикологии, реаниматологии и других дисциплин.
Причины асфиксии
Все причины, приводящие к асфиксическому состоянию, можно разделить на легочные и внелегочные. Первые из них чаще всего связаны с внешним сдавлением дыхательных путей или их внутрипросветной непроходимостью (обтурацией). Компрессия воздухоносных путей извне наблюдается при удушении (повешении, удавлении петлей или руками), сдавлении трахеи, травмах шеи и т. п. Обструктивные расстройства дыхания чаще всего вызываются западением языка, закупоркой трахеи и бронхов инородными телами, внутрипросветными опухолями, попаданием в дыхательные пути пищи, рвотных масс, воды при утоплении, крови при легочном кровотечении. Острый стеноз дыхательных путей может развиваться при трахеобронхите, астматическом приступе, аллергическом отеке или ожоге гортани, отеке голосовых связок. Также к числу легочных причин асфиксии относят нарушения газообмена, вызванные острой пневмонией, массивным экссудативным плевритом, тотальным пневмотораксом или гемотораксом, ателектазом либо отеком легких, ТЭЛА.
Среди внелегочных факторов асфиксии лидируют состояния, приводящие к поражению дыхательного центра: интоксикации, черепно-мозговые травмы, инсульты, передозировка лекарственных и наркотических средств (например, морфина, барбитуратов). Паралич дыхательных мышц, как причина асфиксии, может развиваться на фоне инфекционных заболеваний (ботулизма, полиомиелита, столбняка), отравления курареподобными препаратами, позвоночно-спинномозговой травмы, миастении и пр. Нарушения транспортировки кислорода в ткани возникает при массивных кровотечениях, расстройствах кровообращения, отравлении угарным газом, метгемоглобинообразователями.
В основе травматической асфиксии лежит сдавление или повреждение грудной клетки, затрудняющее дыхательные экскурсии. Асфиксия, вызванная недостаточным содержанием кислорода во вдыхаемом воздухе, может развиваться при длительном пребывании в плохо вентилируемых шахтах и колодцах, при высотной болезни, при нарушении подачи кислорода в ограниченные замкнутые системы (например, у водолазов). К асфиксии новорожденных чаще всего приводят фетоплацентарная недостаточность, внутричерепные родовые травмы, аспирация околоплодных вод.
Патогенез
Механизм развития асфиксии при всех видах удушья имеет общие патогенетические черты. Следствием кислородной недостаточности служит накопление в крови продуктов неполного окисления с развитием метаболического ацидоза. В клетках развиваются тяжелые нарушения биохимических процессов: резко уменьшается количество АТФ, изменяется протекание окислительно-восстановительных процессов, снижается рН и т. д. Следствием протеолитических процессов является аутолиз клеточных компонентов и гибель клетки. Раньше всего необратимые изменения развиваются в клетках головного мозга, а при повреждении дыхательного и сосудодвигательного центров быстро наступает смерть. В сердечной мышце при асфиксии возникают отек, дистрофия и некроз мышечных волокон. Со стороны легких отмечается альвеолярная эмфизема и отек. В серозных оболочках (перикарде, плевре) обнаруживаются мелкопятнистые кровоизлияния.
Классификация
В зависимости от скорости развития удушья (нарушения функции дыхания и гемодинамики) различают острую и подострую асфиксию. По механизму возникновения принято различать следующие виды асфиксии:
- механическую – ограничение или прекращение доступа воздуха в дыхательные пути вызвано их сдавлением, обтурацией или сужением;
- токсическую – удушье развивается в результате угнетения дыхательного центра, паралича дыхательной мускулатуры, нарушения транспорта кислорода кровью в результате попадания в организм химических соединений;
- травматическую - удушье является следствием закрытых повреждений грудной клетки.
Другой вариант классификации предлагает выделять асфиксию от сдавления (компрессионную и странгуляционную – удушение), асфиксию от закрытия (аспирационную, обтурационную, утопление) и асфиксию в ограниченном замкнутом пространстве. Особым видом удушья является асфиксия новорожденных, рассматриваемая в рамках педиатрии.
Симптомы асфиксии
В клиническом течении асфиксии выделяют четыре фазы. Первая фаза характеризуется компенсаторным увеличением активности дыхательного центра в условиях недостатка кислорода. В этот период у пациента возникает испуг, беспокойство, возбуждение; головокружение, цианоз кожных покровов, инспираторная одышка с форсированным вдохом; тахикардия, повышение АД. При асфиксии, вызванной сдавлением или нарушением проходимости дыхательных путей, пациент сильно кашляет, сипит, предпринимает попытки освобождения от сдавливающего фактора; лицо становится одутловатым, багрово-синим.
Во вторую фазу на фоне истощения компенсаторных реакций одышка приобретает экспираторный характер (усиливается и удлиняется выдох), нарастает синюшная окраска кожи, урежается частота дыхательных движений и сердечных сокращений, снижается АД. В третью, претерминальную фазу, происходит кратковременное прекращение активности дыхательного центра: возникают эпизоды апноэ, происходит падение артериального давления, угасают рефлексы, развивается потеря сознания и кома. В последнюю, четвертую фазу асфиксии наблюдается агональное дыхание, отмечаются судороги, пульс и АД не определяются; возможны непроизвольные мочеиспускание, дефекация и семяизвержение.
При постепенно развивающейся асфиксии (в течение нескольких часов или суток) пострадавший сидит, наклонив туловище и вытянув вперед шею; широко раскрытым ртом жадно ловит воздух, язык часто высунут наружу. Кожа обычно бледная, выражен акроцианоз губ и ногтей; на лице отображается страх смерти. При декомпенсации асфиксия приобретает стадийное течение, описанное выше.
Осложнения
Асфиксия осложняется фибрилляцией желудочков, отеком легких и мозга, травматическим шоком, анурией. У беременных может случиться самопроизвольный выкидыш. Причиной гибели пациента обычно служит паралич дыхательного центра. При остром развитии смерть наступает уже через 3-7 минут. В отдаленном периоде у пациентов, переживших асфиксию, могут наблюдаться аспирационная пневмония, парез голосовых связок, различные виды амнезии, изменения эмоционального статуса (раздражительность, безразличие), нарушения интеллекта вплоть до слабоумия.
Диагностика
В острых случаях и при известной причине диагностика асфиксии не представляет трудностей. Если пациент в сознании, он может предъявлять жалобы на головокружение, одышку, потемнение в глазах. Объективные данные зависят от фазы асфиксии. Пульсоксиметрия позволяет определить величину пульса и степень насыщения гемоглобина кислородом. Для выявления и устранения легочных причин асфиксии требуется консультация пульмонолога, иногда – врача-эндоскописта. В остальных случаях к диагностике могут привлекаться травматологи, неврологи, инфекционисты, токсикологи, психиатры, наркологи и др. Диагностический этап должен быть максимально сжатым по времени, поскольку проведение углубленного обследования (рентгенографии, диагностической бронхоскопии и др.) из-за тяжести состоянии больного зачастую фактически невозможно.
Патоморфологическими признаками, свидетельствующими о том, что смерть наступила от асфиксии, служат цианоз лица, кровоизлияния в конъюнктивы, трупные пятна синевато-лилового цвета с множественными экхимозами, жидкое состояние крови, застой крови в правых отделах сердца при пустой левой половине, кровенаполнение внутренних органов и др. При удушении на шее видна странгуляционная борозда от сдавливающей петли, определяются переломы шейных позвонков.
Первая помощь при асфиксии
Комплекс неотложных мероприятий определяется причиной и фазой асфиксии. При механическом удушье, прежде всего, требуется восстановить проходимость воздухоносных путей: удалить скопившуюся слизь, кровь, воду, пищевые массы, инородные тела с помощью трахеальной аспирации, бронхоскопии, специальных приемов; ослабить сдавливающую шею петлю, устранить западение языка и т. д. При отсутствии самостоятельного дыхания и сердечной деятельности переходят к проведению сердечно-легочной реанимации – искусственного дыхания и закрытого массажа сердца. При наличии показаний и технической возможности может производиться трахеостомия или интубация трахеи с переводом больного на аппаратную ИВЛ. Развитие фибрилляции желудочков служит основанием для электрической дефибрилляции.
В некоторых случаях первоочередными мерами по ликвидации асфиксии служат торакоцентез или дренирование плевральной полости. С целью снижения венозного давления выполняется кровопускание. Первая помощь при токсической асфиксии заключается во введении антидотов. После восстановления вентиляции легких и сердечной деятельности производится медикаментозная коррекция водно-электролитного и кислотно-щелочного баланса, поддержание функции сердечно-сосудистой и дыхательной систем, дегидратационная терапия (с целью профилактики отека мозга и легких), переливание крови и кровезамещающих растворов (при обильной кровопотере). Если причиной асфиксии явились другие заболевания (инфекционные, нервные и др.) необходимо проведение их патогенетического лечения.
Прогноз и профилактика
При остро прогрессирующей асфиксии прогноз чрезвычайно серьезный - имеется высокий риск летального исхода; при затяжном развитии – более благоприятный. Однако даже в тех случаях, когда удается восстановить жизненно важные функции, последствия асфиксии могут дать о себе знать в ближайшее или отдаленное время после выхода больного из критического состояния. Исход асфиксии во многом предопределяется своевременностью проведения и объемом реанимационных мероприятий. Профилактикой асфиксии служит недопущение ситуаций, которые могут вызвать удушье: раннее лечение потенциально опасных заболеваний, предупреждение травм грудной клетки, аспирации жидких веществ и инородных предметов, суицидов; исключение контакта с токсическими веществами (в т. ч. лечение токсикомании и наркомании) и др. После перенесенной асфиксии больным нередко требуется тщательный уход и длительное наблюдение специалистов.
1. Механическая асфиксия: судебно-медицинская диагностика и оценка: Учебное пособие/ Витер В.И., Вавилов А.Ю., Кунгурова В.В., Бабушкина К.А. - 2016.
2. Асфиксия новорожденных. Перинатальная патология нервной системы: Учебное пособие/ Ткаченко А.К. - 2006.
3. Позиционная асфиксия/ Козлов С.В., Сулоев К.Н., Алексин Г.Б., Ткаченко А.В.//Морфология. - 2016 - Т10, №
4. Первая медицинская помощь при разных несчастных случаях. Шок. Асфиксия. Повешение или странгуляционная асфиксия. Травматическая асфиксия. Заваливание. Утопление: Методич. указания/ Сост. В.В. Голикова, Г.Г. Роман, О.И. Шевченко. - 2013.
Странгуляционная асфиксия ( Механическая асфиксия , Удавление , Удушение )
Странгуляционная асфиксия — это одна из форм механической асфиксии, возникающая в результате сдавливания кровеносных сосудов и дыхательных путей в верхних отделах. Является следствием удушения с использованием самозатягивающейся петли или удавки. Сопровождается развитием судорог, потерей сознания, нарушением или остановкой дыхания, непроизвольной дефекацией и мочеиспусканием, диффузным цианозом кожи. При компрессии более 4-5 минут наступает смерть. Патология диагностируется визуально по наличию характерных симптомов и странгуляционной борозды. Специфическое лечение: освобождение шеи, обеспечение адекватного дыхания с помощью ИВЛ или инсуффляции кислорода, тотальная релаксация курареподобными препаратами, симптоматическая терапия.
Странгуляционная асфиксия (механическая, удавление) характеризуется резким ослаблением кровотока в головном мозге, уменьшением концентрации кислорода, тяжелой гипоксией. В зависимости от использованного типа петли может являться полной или неполной. Диагностируется при попытках повешения или в результате криминальных действий. Количество случаев суицидального удавления увеличивается весной и осенью, в период обострения у психиатрических больных и высокой распространенности депрессивных состояний. Около 70% людей, выбравших данный способ самоубийства, являются мужчинами. Ситуации, связанные с уголовными преступлениями, чаще возникают в крупных городах.
Причины
Непосредственная причина странгуляционной асфиксии — механическое пережатие верхних дыхательных путей и кровеносных сосудов удушающим предметом, в качестве которого может выступать самозатягивающаяся или несамозатягивающаяся петля, удавка. При этом возникает механическое препятствие для прохождения крови к головному мозгу, нарушается целостность хрящевых колец трахеи. Криминогенные удавления происходят при ограблении, покушении на убийство. К суицидальным попыткам предрасполагают следующие факторы:
- Проблемы в личной жизни. Подобные мотивы чаще встречаются у людей в возрасте 15-29 лет. Совершить самоубийство пытаются подростки, имеющие сложности в отношениях с родителями, страдающие от неразделенной любви и состоящие в сектах различной направленности. Это обусловлено возрастной или конституциональной незрелостью психики, желанием уйти от имеющихся трудностей.
- Психические заболевания. Попытки суицида при болезнях психиатрического профиля широко распространены, их количество достигает 50% от общего числа случаев. Убить себя пытаются люди, находящиеся в маниакальной стадии МДП, имеющие диагностированную шизофрению и алкогольный психоз, не отдающие себе отчета в своих действиях. Чаще суицидальные попытки происходят при обострениях.
- Безвыходные ситуации. К числу обстоятельств, при которых возможен суицид, относятся банкротство, нищета, потеря единственного источника дохода, утрата жилья или возможностей его приобретения. Добровольный уход из жизни нередко совершают люди, опасающиеся наказания за совершенные поступки, находящиеся под угрозой уголовного преследования, в том числе пожизненного или чрезмерно долгого, по их мнению, срока тюремного заключения.
- Психологический стресс. Известны случаи, когда самоповешение совершали люди, недавно пережившие развод, подвергшиеся сексуальному насилию, вынужденные произвести неприемлемое для них действие (убийство, предательство). Возможны и другие причины, объединенные наличием сильнейшего психологического потрясения, пережить которое пострадавший оказался неспособен.
- Тяжелые соматические заболевания. Значительное количество суицидальных попыток совершается пациентами, страдающими неизлечимыми онкологическими процессами. Самоубийство среди таких больных — способ ускорить неизбежное, остановить мучения, возникающие из-за выраженного болевого синдрома. Самостоятельное прекращение существования также практикуется пациентами, имеющими патологию, снижающую качество жизни: слепоту, паралич конечностей.
Удавление бывает полным или неполным. В первом случае тело целиком находится в воздухе, во втором частично опирается на какую-либо поверхность. Смерть или тяжелая гипоксия может наступить в обеих ситуациях, поскольку сонные артерии сдавливаются уже при нагрузке в 4-5 кг, позвоночные — 15-20 кг. При ударном усилии (прыжок с табуретки) и низком расположении удушающего агента происходит перелом подъязычной кости и полуколец трахеи. Плавное затягивание петли к подобным последствиям не приводит.
В момент остановки кровотока быстро нарастают расстройства газообмена по типу гипоксемии и гиперкапнии, возникает кратковременный спазм сосудистой сети с ее последующим стойким расширением. Отмечается значительное повышение венозного давления в церебральных бассейнах. При вскрытии обнаруживаются множественные мелкие кровоизлияния в ретробульбарную клетчатку, толщу грудино-сосцевидно-подключичных мышц и межпозвонковые диски. Могут выявляться разрывы интимы сонных артерий, участки некроза тканей головного мозга (ишемический инсульт).
Странгуляционная асфиксия приводит к гибели в несколько этапов. Каждый из них продолжается 30-60 секунд. Иногда процесс затягивается до 10 минут. Длительность периода, предшествующего наступлению клинической смерти, зависит от локализации удавки, механических свойств материала, из которого состоит петля, и толщины травмирующего агента. Быстрее всего человек погибает при расположении борозды выше гортани. При этом происходит сжатие каротидных синусов, коллапс сосудов и рефлекторная остановка дыхания. Последствия удавления напрямую зависят от того, на какой стадии оно было прервано. Специалисты в области клинической реаниматологии различают следующие степени асфиксии:
- I степень. Характеризуется появлением тахикардии, признаками умеренной дыхательной недостаточности, цианозом кожных покровов, участием в процессе дыхания межреберных мышц, трепетанием крыльев носа, ростом артериального и венозного давления. Сознание сохраняется, психическое состояние может быть изменено. В большинстве случаев не имеет отдаленных последствий.
- II степень. Развивается через 2-3 минуты при полном удавлении и через 1-2 минуты при неполном. Дыхание редкое, присутствуют мышечные судороги. Может произойти непроизвольное мочеиспускание, опорожнение кишечника. Сознание утрачено или пациент находится в глубоком оглушении. У спасенных на этом этапе в дальнейшем развиваются нарушения чувствительности, умеренные неврологические изменения.
- III степень. Длительность варьируется от нескольких секунд до 1-2 минут. Возникает временная остановка дыхания, это явление называется терминальной паузой. Сохраняются судорожные сокращения мышц и атония сфинктеров, артериальное давление снижается до критически малых и неопределяемых величин. Нарастает диффузный цианоз. Пациенты, подвергшиеся реанимации, в последующем страдают от тяжелых нарушений работы ЦНС.
- IV степень. Самостоятельное дыхание возобновляется, однако имеет патологический характер (Чейна-Стокса или Куссмауля). Через несколько минут наступает его полное прекращение. Сопровождается остановкой сердца. Диагностируется клиническая смерть. У больных, которых удалось спасти, обнаруживаются симптомы постреанимационной болезни, неврологический дефицит, в отдельных случаях смерть мозга (декортикация).
Симптомы странгуляционной асфиксии
После удаления травмирующего фактора удавление приводит к появлению определенного симптомокомплекса. У большинства больных сознание отсутствует. При его сохранении человек ведет себя неадекватно, бывает агрессивным. Исключение составляют случаи удавления, которое удалось прервать на первом этапе. На шее заметен характерный след травмы — странгуляционная борозда. Скелетная мускулатура напряжена, отмечаются непрерывные судороги. На склерах и конъюнктиве глаза, а также на слизистой оболочке рта, верхнем и промежуточном валике борозды обнаруживается петехиальная сыпь.
Дыхание пациента аритмичное, порой прерывистое. При удавлении с помощью незатягивающихся петель развивается анизокория, спровоцированная односторонним сжатием симпатического нерва. Осмотр позволяет выявить положительный симптом Миновичи — закусывание кончика языка передними зубами во время судорог. Из носовых ходов выделяется сукровичная жидкость, артериальное давление повышено или резко снижено, имеет место тахикардия, нарушение коронарного ритма.
Распространенным осложнением странгуляционной асфиксии считается постгипоксическая энцефалопатия. Она встречается более чем у 70% людей, подвергшихся удавлению II-IV степени. Тяжесть последствий напрямую зависит от этапа, на котором был спасен пострадавший, и времени, потребовавшегося для коррекции газового состава крови. Патология проявляется хроническими головными болями, снижением умственных способностей, нестабильностью психики, паническими атаками или приступами агрессии.
Поражение центральной нервной системы становится причиной соматических сбоев. У 20-40% людей развиваются параличи и парезы различной степени. Возможно нарушение функций верхних или нижних конечностей, корпуса. Лица, перенесшие перелом хрящевых структур трахеи, в последующем в 80% случаев испытывают трудности с дыханием, может возникать стеноз ВДП, склонность к бронхоспазму. Подобные осложнения редко удается устранить. Подавляющее большинство больных подвергаются значительному падению качества жизни, иногда пациенты совершают повторные попытки суицида, спровоцированные ухудшением здоровья.
Постановка диагноза странгуляционная асфиксия производится на основании анамнестических данных и имеющейся на момент осмотра клинической картины. Определить произошедшее врачу скорой помощи, прибывшему на место происшествия, позволяет и окружающая обстановка: остатки петли на потолке, предсмертная записка, следы дефекации на одежде пострадавшего. Лабораторное изучение осуществляется в стационаре для определения тяжести нарушений гомеостаза. Визуализирующие методики позволяют установить факт механической деструкции образований шеи. План работы с пациентом включает в себя следующие пункты:
- Лабораторное обследование. Показан анализ на КЩС, концентрацию газов в крови. Содержание CO2 повышено, концентрация кислорода снижена. Отмечаются признаки метаболического ацидоза — снижение pH
- Аппаратное обследование. Выполняется рентгенография шеи, при необходимости и наличии технической возможности — компьютерная томография пораженной области. При проведении КТ удается создать трехмерное послойное изображение необходимой зоны, тем самым определив не только наличие, но и точную локализацию повреждений, вызванных сдавлением.
- Психиатрическое обследование. Людям, совершившим попытку суицида, рекомендована консультация психиатра. В ходе беседы врач выявляет причины решения о смерти, определяет уровень адекватности больного. Пациенты, имеющие признаки сохраняющихся расстройств (агрессия, депрессивные состояния, несоответствие поведения окружающей обстановке) подлежат дальнейшему лечению в стационаре соответствующего профиля.
Неотложная помощь
Лечение состоит из двух этапов — догоспитального и госпитального. Первый продолжается с момента обнаружения пострадавшего до его доставки в стационар. Действие удушающего фактора должно быть прекращено как можно скорее. Больного необходимо уложить на спину, оценить состояние. Неадекватное самостоятельное дыхание или его отсутствие — показание для интубации трахеи. Если пациента не удается интубировать, применяется коникотомия. ИВЛ проводят в режиме небольшой гипервентиляции с содержанием кислорода в смеси на уровне 60-70%. Требуется введение бензодиазепинов, кристаллоидных растворов, натрия гидрокарбоната, мочегонных средств и преднизолона. Транспортировку осуществляют после фиксации шеи шиной-воротником.
В стационаре анестезиолог-реаниматолог продолжает начатые бригадой СМП восстановительные мероприятия. Больного помещают в ОРИТ, подключают к аппарату ИВЛ. Искусственную вентиляцию продолжают не менее 4 часов, чаще до 2-3 суток. Для купирования гиперкоагуляции используют гепарин, судороги считаются показанием для полной мышечной релаксации за счет периферических миорелаксантов. Проводится массивная инфузионная терапия, коррекция метаболических сбоев. В первый день требуется круглосуточный контроль витальных функций с помощью анестезиологического монитора. Если пациент в сознании, рекомендована мягкая фиксация к кровати или индивидуальный сестринский пост (профилактика рецидивов суицида).
Прогноз для жизни благоприятный. В абсолютном большинстве случаев пострадавшего, обнаруженного до момента остановки сердца, удается спасти. Выздоровление бывает неполным. Отсроченные последствия возникают практически у всех пациентов, перенесших удавление второй и более степени. Тяжесть отдаленной патологии зависит от выраженности и продолжительности гипоксии мозга, расположения и свойств петли, имевшихся до суицида неврологических или психических заболеваний.
Странгуляционная асфиксия криминогенного характера по понятным причинам не поддается медицинской профилактике. Суицидальные попытки пресекаются за счет внимательного наблюдения за окружающими. Эта задача возлагается на родственников и близких каждого человека. Должна быть хорошо организована служба психологической помощи, работа групп поддержки для людей, попавших в трудные жизненные ситуации. Во все виды диспансеризации и профессиональной медицинской комиссии рекомендуется включать осмотр психиатра.
1. Руководство по скорой медицинской помощи / Багненко С.Ф., Верткин А.Л., Хубутия М.Ш. и др. – 2007.
3. Лекция №12, асфиксия. Стадии нарушения внешнего дыхания / Чеснокова Н.П., Полутова Н.В. // Научное обозрение – 2017 - №2.
Изменения в фасциях и нервах шеи при сдавлении петлей. Внутренние органы при повешении
В последнее время в связи с достижениями в области изучения микроциркуляции появилась возможность получения новых данных о прижизненном воздействии петли по состоянию микроциркуляторного русла в фасциях шеи. На препаратах, нмпрегиированных азотнокислым серебром по В. В. Куприянову, в фасциях шеи за пределами краевых валиков, так же как в серозных оболочках (плевре, брюшине, перикарде), на фоне общего сужения артериол и прекапилляров наблюдают наличие участков еще большего сужения, имеющих вид перетяжек, отмечают закрытие артериального сегмента артериовенулярных анастомозов, в то время как венулярный сегмент расширен и наполнен кровью.
Капиллярная сеть характеризуется извитостью. Посткапилляры и венулы фрагментарно расширены, переполнены кровью, напоминают цистерны. В сосудах образуются агрегаты эритроцитов. Ядра эндотелия набухшие, и в то же время расстояния между ними увеличены. Таким образом, детальное исследование состояния микроциркуляции показывает, что при странгуляционной асфиксии смена первой фазы сосудистой реакции отчетливо выражена только в венозном русле, которое представляется расширенным. В артериальном русле полного разрешения спазма не происходит — артериолы кажутся уменьшенными в диаметре. Кроме того, многие из них имеют «перетяжки».
В шейной части ствола блуждающего нерва и его ганглиях отмечают очаги демиелинизации, неравномерную импрегнацию, разрывы аксонов, наплывы миелина; в нижнем ганглии — аргентофилию и гомогенизацию нейрофибрилл, неравномерное распределение базофильных субстанций (Ниссля) в ганглиозных клетках, хроматолиз, пнкноз и эксцентричное расположение ядер во многих клетках. Однако использовать указанные признаки для решения вопроса о прижизненности странгуляции можно с большой осторожностью (с учетом возрастной морфологии) .
Большее значение следует придавать кровоизлияниям. Они встречаются в шейной части стволa и ганглиях блуждающих нервов и в верхних шейных симпатических узлах.

Внутренние органы при повешении
При микроскопическом исследовании обращают внимание на признаки нарушения органного кровообращения, явления повышения проницаемости сосудистых стенок, острые дистрофические изменения.
В легких за счет наличия очагов отека, геморрагии, ателектаза отмечают некоторое понижение воздушности ткани. Они могут быть небольшими — в пределах нескольких альвеол или более крупными. Эти изменения наиболее выражены в периферических участках легких.
В других отделах они могут быть одиночными или чередоваться с группами эмфизематозно растянутых альвеол. В отечных альвеолах можно увидеть десквамированные пневмоциты и альвеолярные фагоциты. Капилляры межальвеолярных перегородок во многих местах переполнены кровью. Полнокровны также внутридольковые и междольковые сосуды; окружающая их соединительная ткань разрыхлена, коллагеновые волокна набухшие. Аргирофильные волокна легочного каркаса импрегнируются серебром слабо, так что иногда можно говорить об их «коллагенизации». Недостаточно четко аргирофильные волокна выявляются и в сосудах мелкого и среднего калибра.
Странгуляционная асфиксия ( повешение ). Этиология ( причины ), патогенез странгуляционной асфиксии. Клиника странгуляционной асфиксии. Неотложная помощь при странгуляционной асфиксие.
Странгуляционная асфиксия (повешение) характеризуется как синдром острой дыхательной и сердечно-сосудистой недостаточности, возникающий в результате механического пережатия шеи.
Этиология. Наиболее частые причины — суицидальные попытки или несчастные случаи, связанные с механическим пережатием шеи.
Патогенез складывается из 4-х основных компонентов:
1. Механическое сдавление шеи петлей в результате смещения и прижатия языка к задней стенке глотки блокирует проходимость верхних дыхательных путей, что вызывает развитие ОДН, последовательно протекающей в четыре стадии продолжительностью от нескольких секунд до нескольких минут. Для первой стадии характерны попытки провести глубокий форсированный вдох с участием вспомогательных мышц. Быстро появляется и нарастает цианоз кожных покровов, артериальная и венозная гипертен-зия, тахикардия. При второй стадии больной теряет сознание, появляются судороги, непроизвольное мочеиспускание. АД снижается, дыхание становится аритмичным, урежается. В третьей стадии наступает остановка дыхания, в четвертой — смерть.
2. Пережатие вен шеи на фоне сохраненной проходимости артерий сопровождается быстрым переполнением венозной кровью сосудов головного мозга, в результате чего повышается внутричерепное давление.
3. Механическая травма каротидного синуса приводит к рефлекторным нарушениям со стороны ССС.
4. Возможно механическое повреждение шейного отдела позвоночника и спинного мозга.

Клиника. При осмотре обращает на себя внимание нарушение жизненно важных функций организма. Состояние сознания — от спутанного до полного отсутствия; кожные покровы бледные, ак-роцианоз. Характерен судорожный синдром с выраженным напряжением мышц спины и конечностей; непроизвольное моче- и ка-лоотделение. Отмечается также расширение зрачков, отсутствие их реакции на свет, нистагм. На внутренней поверхности век и склер часто отмечаются мелкоточечные кровоизлияния. Нарушения со стороны ССС наиболее часто возможны по двум вариантам: тахикардия до 160—180 в 1 мин. и артериальная гипертензия до 200 мм рт. ст. и более или гипотензия в сочетании с брадикардией, что является неблагоприятным диагностическим признаком (смертность в данной подгруппе в 3 раза выше).
Неотложная помощь. Отдаленные результаты лечения во многом зависят от своевременности и правильности оказания медицинской помощи на догоспитальном уровне. Идеальным вариантом лечения является использование миорелаксантов с последующей интубацией трахеи и проведением аппаратной ИВЛ на месте происшествия. При отсутствии на этапе скорой помощи возможности осуществить данное пособие, на первый план выходит купирование судорожного синдрома.
для этой цели является в/в введение 2—4 мл реланиума на 10—20 мл физраствора. Данная доза позволяет купировать судорожный синдром в 70—80% случаев. При необходимости, через 5—10 мин. можно повторить введение реланиума. В остальном терапия на догоспитальном этапе носит симптоматический характер. Проведение патогенетической терапии (введение спазмолитиков, диуретиков, раствора соды) целесообразно начинать на догоспитальном этапе, если время эвакуации пострадавшего будет превышать 30—40 мин.
Примечание. Введение дыхательных аналептиков при данной патологии нецелесообразно, так как они повышают потребность клеток головного мозга в кислороде, что может углубить его ишемию и вызвать или усилить имеющийся судорожный синдром.
Стационар. Принципы лечения
1. Купирование судорожного синдрома.
2. Проведение ИВЛ по показаниям (наличие ОДН II—III ст.).
3. Купирование отека головного мозга.
4. Коррекция КЩС и электролитного состояния.
5. Профилактика гипостатических осложнений.
6. Антибиотикотерапия.
7. При наличии гипоксической энцефалопатии показано проведение гипербарической оксигенации (ГБО).
8. Симптоматическая терапия.
Читайте также:
